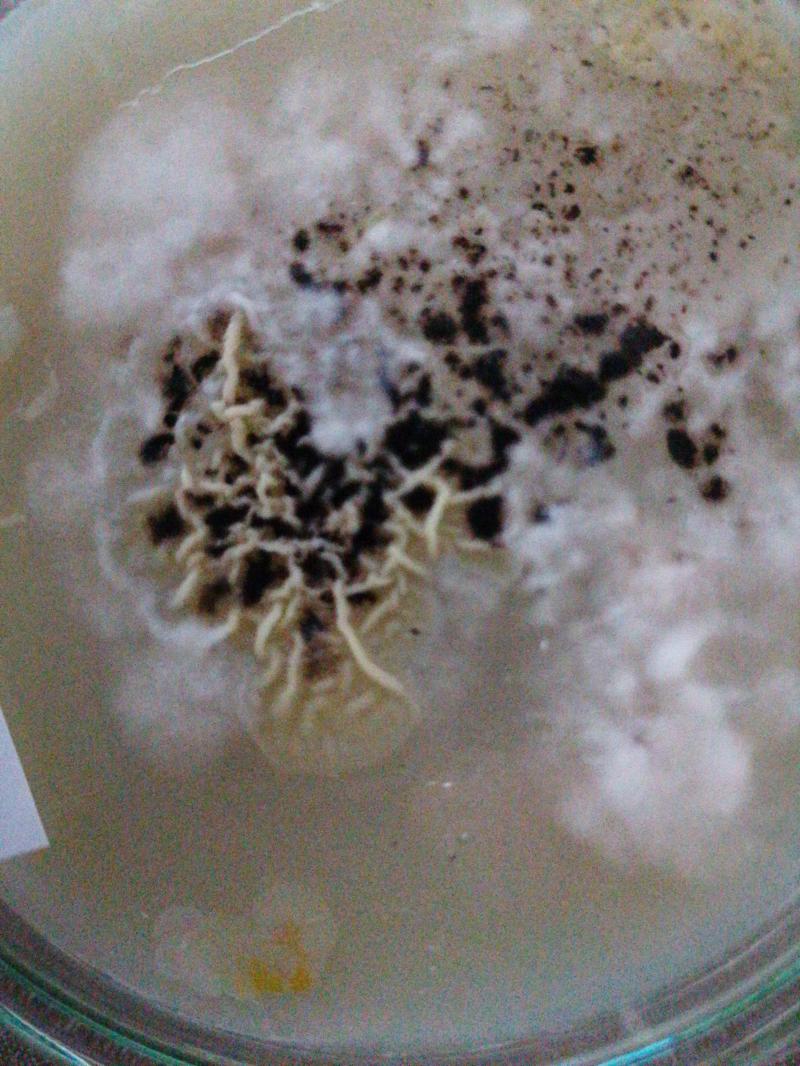
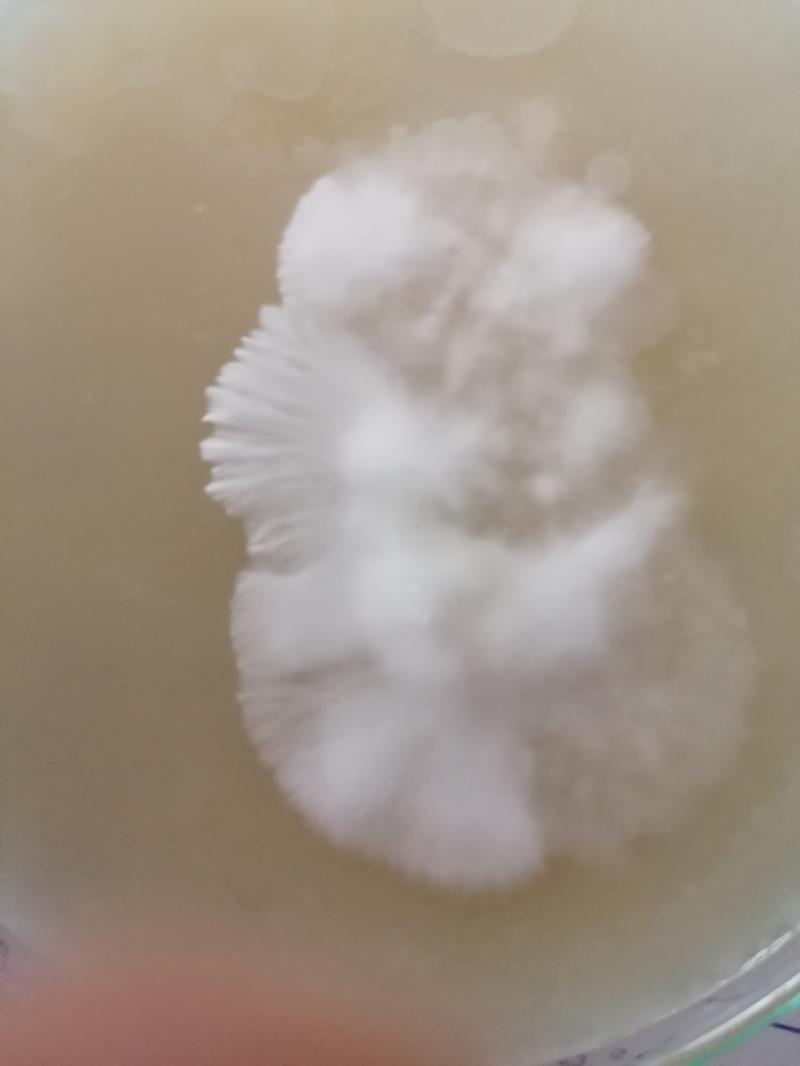
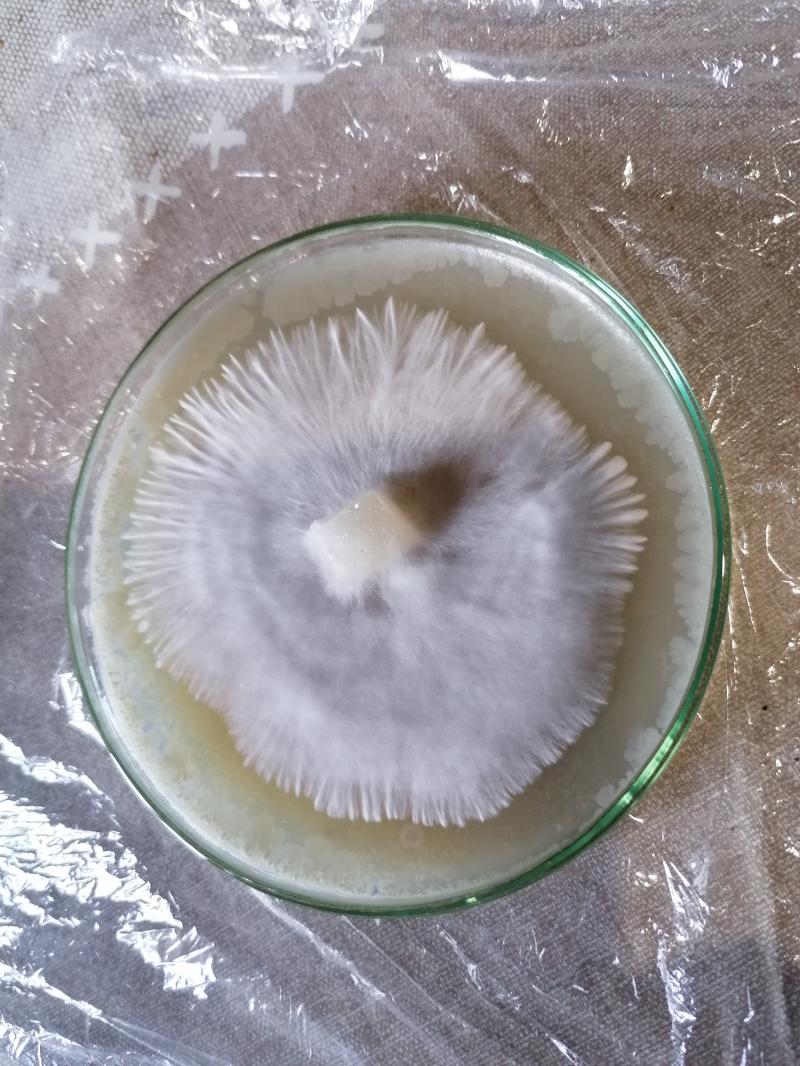

[ Culture ]
Comment faire fruiter du mycelium sur seigle
- Shenmen

Nouveau membre
- 28 mars 2021 à 20:45
On sent l'aspect vivant de la masse que s'agglutine je trouve.

Et là j'ai une gélose qui réagit.
Ça a l'air pas trop mal à vu d'œil, même si la gélose semble un peu "frippée" par endroit.
Qu'en dites vous ?
Hors ligne

- MikeO'ryize

Psycho junior
- 29 mars 2021 à 23:12

La fin est en germe dans le début
Hors ligne

- MikeO'ryize

Psycho junior
- 29 mars 2021 à 23:21

Et tout en bas aussi ça ressemble fort à des contaminations. Mais c'est pas tout à fait étonnant, ça veut pas forcément dire que t'as mal manipulé, les spores ne sont jamais propres à 100%.
Maintenant ce qu'il faut que tu fasses, c'est prendre un petit bout de gélose, loin des spores, qui semble bien blanc et propre et le transférer sur une autre gélose. Il faut faire ça plusieurs fois jusqu'à avoir la gélose complètement clean juste avec le mycélium dessus. et après tu peux faire coloniser du grain juste avec des morceaux de géloses, ou tu fais une culture liquide à partir d'un morceau de gélose propre
PS: La photo des spores dans l'eau est super belle !
La fin est en germe dans le début
Hors ligne
- Shenmen

Nouveau membre
- 30 mars 2021 à 21:19
Pour le coup mes champi ont pas bcp poussé en 1 j, je viens de jeter un œil et pof, une belle conta qui s'est incrusté dans le milieu de culture.
Pourtant j'ai pas ventilé le sac donc y'a pas eu d'entrée extérieur. Peut être trop d'humidité et ça favorise l'émergence d'autres individus. C'est possible ça ?
Ça m'a l'air très rapide à se développer, j'ai rien vu ce matin, mais le sac est un peu flouté par l'humidité donc j'ai peut être focalisé mon regards sur les champignons.
Je met la photo pour vous montrer.
Va falloir encore un peu de patience on dirait avant de choper le truc.

Hors ligne

- MikeO'ryize

Psycho junior
- 30 mars 2021 à 23:06
La fin est en germe dans le début
Hors ligne
- Shenmen

Nouveau membre
- 30 mars 2021 à 23:33
C'est un peu comme quand tu jouais à Mario bros sur super nes, t'es au boss de fin et là crack, il te touche et tu dois recommencer le niveau.
Heureusement pour moi j'ai encore pas mal de vies, avec des sacs colonisés ou en bonne voie, et j'ai 2 autres tests qui ont commencé à fruitier.
Et pour filer la métaphore jusqu'au bout, dans le besoin mange un champignon, et comme Mario, avec succès tu finiras le niveau ??
Affaire à suivre...
Hors ligne

- MikeO'ryize

Psycho junior
- 30 mars 2021 à 23:42
Si c'est pas déjà fait je te conseille vivement de jeter le pain contaminé, c'est un coup a contaminer le reste. Hâte de te voir passer le niveau en tous cas, affaire à suivre comme tu dis
La fin est en germe dans le début
Hors ligne
- Shenmen

Nouveau membre
- 31 mars 2021 à 10:01
Oui j'ai jeté direct le pain dehors

Hors ligne
- Shenmen

Nouveau membre
- 12 avril 2021 à 16:48
Petite photo de gelose transplanté, le dessin est super joli, ça m'a l'air clean et j'avais dit que je partagerai l'avancée alors voilà :)
Pour le reste j'ai eu un pain qui donne des primordia, j'espère que la croissance va se poursuivre completement.
Je reviendrai avec des images quand ça sera le cas.

Bonne journée !
Hors ligne

- MikeO'ryize

Psycho junior
- 12 avril 2021 à 23:03

Bonne journée à toi !
La fin est en germe dans le début
Hors ligne

- SillyCone

Ex-penseur de conscience
- 12 avril 2021 à 23:40
Shenmen a écrit
Mais donc on pasteurise le substrat sans avoir besoin de stériliser finalement ?
Car avec du mycelium bien fort, on a une longueur d'avance sur les concurrents potentiels c'est ça ?
La pasteurisation détruit les germes nocifs pour le mycélium et laisse vivant les germes symbiotiques qui protègent le mycélium et qui tiennent les germes nocifs "en joue".
Alors que si on stérilise le substrat, à la moindre prise d'air, les spores présents dans l'air le colonisent et attaquent le mycélium. Donc si on stérilise, il faut rester en stérile, travailler avec un flux laminaire ou une glovebox bien nettoyée. Ce qui est faisable dans un sac de 3L, mais pas avec des quantités de bulk. Donc sans grand intérêt...
Shenmen a écrit
Et je mélange ça à mon grain colonisé dans une boîte pour faire fruitier si j'ai bien compris ?
Yup, je crois que tu verras ça dans un (ou plusieurs) de mes tutos épinglés.
Je ne réponds pas aux demandes d'information par MP.
Faites les en public que tout le monde puisse y répondre.
Gratitude
Hors ligne
- Shenmen

Nouveau membre
- 13 avril 2021 à 10:36

Okay merci pour l'info Silly one je savais pas du tout pour la pasteurisation, c'est très bon à savoir
Yep, je vais jeter un œil dans tes tutos pour éplucher tout ça :)
Bonne journée !
Hors ligne
- Shenmen

Nouveau membre
- 21 avril 2021 à 19:06
3 génération de mycélium sur gélose, c'est magnifique

Petite photo pour montrer l'évolution.
À bientôt !
Hors ligne

- MikeO'ryize

Psycho junior
- 21 avril 2021 à 22:43
Ca a donné quoi le reste de tes graines dans les sacs ?
La fin est en germe dans le début
Hors ligne
- Shenmen

Nouveau membre
- 23 avril 2021 à 16:56
Oui sur le contour je sais pas, peut être la gélose oui, mais je vais refaire la session d'agar pour être sûr que ce soit bien propre.
Pour mes autres sacs, j'attends que ça pin, j'en ai eu un qui a commencé à donner quelques jolis spécimens mais y'a encore un peu de bouleau avant que je sois vraiment satisfait.
C'est un de premiers test que j'avais fait simplement en mettant une couche de vermi sur du grain 100%.
En ouvrant le sac 1x/j les champ se sont vraiment développé tandis qu'à mes premiers essais j'arriverais pas jusqu'à la maturité complète.
Tu renouvelles l'air à quelle fréquence pour te débarrasser du co2 et faire tomber un petit peu le taux d'humidité ?
Voici une photo. C'est le 3e flush là je crois. Par contre j'ai l'impression qu'ils sont bien plus denses que ce que j'ai pu avoir avec des kits trouvés dans le commerce.
J'ai fait 3 tests cvg lancé le 6 mais ça pin toujours pas.
Tu as une stratégie particulière pour faire sortir les pinheads ou tu places en fructif et tu laisses les choses se faire d'elles même ?
Et d'autre en crotin/paille et crotin/vermi pour tester.
En tout cas j'ai bien progressé depuis le début de ce post

Affaire à suivre


Hors ligne

- MikeO'ryize

Psycho junior
- 24 avril 2021 à 11:38
J'ouvres mes boites une fois pas jour et je ventile avec le couvercle une trentaine de fois et je pulvérise un peu d'eau à ce moment là dans la boite. Mais que pour les boites qui sont suffisamment colonisées que je lance en fructification.
Les micro gouttelettes aident à la formation des primordia apparement donc j'essaye d'avoir ces petites goutes sur le substrat quand je lance la fructification.
Du coup j'ai des petites aérations sur mes boites, donc pendant la colonisation je les ferme avec su scotche normal. Et dès que le substrat est colonisé comme je veux, je remplace le scotche normal par le scotche microport. Ca permet de faire circuler plus l'air, et en plus de ça j'aère une fois par jour en pulvérisant super fin de l'eau sur le substrat. Et normalement avec l'apport en oxygène, les microgoutelettes et la lumière du jour indirecte ça suffit à lancer la fructification.
J'ai lancé un substrat CVG avec des PF-tek râpées le 6 avril et les premières pinheads apparaissent en ce moment donc ça fait 17 jours pour la colonisation et la fructification. Ce qui me semble plûtot raisonnable. Mais par exemple pour celui la j'ai rien changé du tout, pour moi il n'était pas suffisamment colonisé, mais les pinheads sont arrivées toutes seules.
J'ai lancé un autre bac encore avec un substrat CVG mais cette fois ci avec du grain et là ça a colonisé en 5 jours et j'ai mis le scotche microport, j'aère et j'arrose pour lancer la fructification. On va voir en combien de temps ça arrive comme ça.
Ma température est a 22,5 dans ma serre, il faut qu'il fasse un peu moins chaud pour la fructification que pour la colonisation des substrats
Tu fais quoi toi pour lancer la fructification ?
Ca fait pas mal de test ! Je suis curieux de voir si tu t'en sors avec les substrats nutritifs, et si c'est le cas faudra que je choppe des conseils auprès de toi parce que j'ai vraiment toujours galéré avec ça.
Effectivement j'ai l'impression que t'as chopé pas mal de techniques et de savoirs faire différents par rapport au point de départ et ça fait super plaisir. Il ne manque plus qu'un peu plus de pratique pour consolider tout ça et appliquer ces connaissances ! :)
La fin est en germe dans le début
Hors ligne
- Shenmen

Nouveau membre
- 25 avril 2021 à 21:58
Je réfléchis au process... Je dunk après colonisation du substrat avant le passage en fruitaison, c'est peu être en trop ? Je vais essayer sans pour voir.
Sinon une fois le grain colonisé, je mélange au substrat, en proportion d'1/5e de grain et j'envoie le tout à 28° à l'incubateur. Quand ça commence à être bien blanc sur le dessus et que le substrat à bien pris, je dunk et je met à 24° avec lumière indirect du soleil, aération 1 à 2 x /j durant 20sec en ventilant légèrement. Comme j'ai pas mal de condensation du au dunk je pense, j'apporte pas trop d'eau avec le spray.
Et ensuite ben.... J'attends lol
Là je reproduit bien mes grains avec de l'agar c'est rapide et ça donne un super mycélium.
Et en parallèle j'améliore la génétique d'agar en agar avec pas mal de boîtes pour avoir de quoi tester, faire des CL etc...
Aussi, j'ai eu un petit soucis de grain qui partait en boullit dans le sac. Après réflexion je pense que j'inoculais peut être trop vite une fois sortit de la stérilisation. Ça met un peu d'humidité à l'intérieur du sac forcément, et là je laisse un bon 24h et l'humidité semble être reabsorbee par le grain et ça donne une colonisation plus propre du coup.
Voilà, c'est pas encore tout à fait ça mais je sens que je m'approche, encore un peu de pratique pour consolider tout ça comme tu dis

La suite au prochain épisode

Dernière modification par Shenmen (25 avril 2021 à 21:59)
Hors ligne

- MikeO'ryize

Psycho junior
- 27 avril 2021 à 19:32
C'est peu-être ton ratio grain/substrat qui est un peu faible. Forcément plus il y a de grain plus ton substrat colonise vite, mais encore pas sur que ça aide à avoir des pinheads plus vite. Juste une colonisation plus accélérée.
Faut que tu prennes ton mal en patience, pour moi il n'y a pas de problème dans le process, tout m'a l'air correcte.
Pour le grain en bouillie, c'est peut-être lié à la cuisson, genre des grains éclatés. Et effectivement après la mise en sac, c'est bien de secouer un peu le grain pour que l'eau soit réabsorbée après la cuisson de manière homogène.
Les récoltes en abondance sont à portée de main, on contera bientôt un nouveau sensei de la mycologie sur PA !

Dernière modification par MikeO'ryize (27 avril 2021 à 19:33)
La fin est en germe dans le début
Hors ligne
- Shenmen

Nouveau membre
- 27 avril 2021 à 21:34
Pourtant justement niveau grain je dose bien, peut être même trop (25% environ) pour 75% de substrat et encore des fois j'ai mis plus pour pallier à mon impatience lol.
En tout cas, c'est bien fichu, car comme je rame sur la dernière étape, je suis obligé de faire plusieurs fois les autres étapes précédentes et je commence à bien m'en sortir et à gagner en vitesse.
J'ai eu un sac de 1kg de grain colonisé entièrement en 1 semaine sans secouer.
Aussi je multiplie les méthodes d'inoculation pour voir les variations de vitesse de colonisation.
Oui pour le grain en bouilli ça doit être que quelques grains éclatés ainsi qu'une humidité none réabsorbé viennent mettre la pagaille, mais sur le dernier coup que j'ai fait ça semble être réglé.
J'ai une bonne hygrométrie dans mes bags mais quand même le pain réduit de taille par rapport au bord de la boîte, ce qui me fait penser qu'il sèche tout simplement... Je vais réajuster mon process de dunk en laissant peut être quelques heures en plus avec le trempage pour qu'il s'imprègne davantage avant de passer en fructif.
Allez go ! On y croit ?
See you !
Hors ligne
Sujets similaires dans les forums, psychowiki et QuizzZ
- Psychoactif » Forums
- » Enthéogènes
- » Psilocybe - Champignon magique - Truffe
- » [ Culture ] Comment faire fruiter du mycelium sur seigle
Affichage Bureau - A propos de Psychoactif - Politique de confidentialité - CGU - Contact -

 Soutenez PsychoACTIF
Soutenez PsychoACTIF